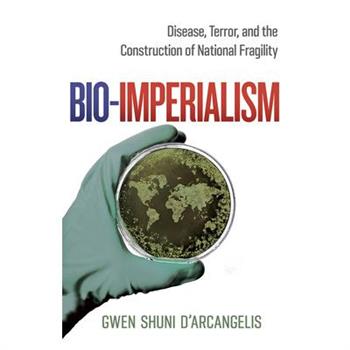
Bio-Imperialism

-
Bio control of Industrial Biofilms
Biofilm is a common mode of bacterial growth on organic or inorganic surfaces in contact with
-
Bio controllo dei biofilm industriali
Biofilm 癡 una modalit? comune di crescita batterica su superfici organiche o inorganiche a co
-
Einheilung von Implantaten und Bio- Integration von Implantaten
In der Zahnheilkunde wurden in den letzten Jahrzehnten zunehmend enossale (im Knochen sitzende) Imp
-
Cura de Implantes e Bio- Integra癟瓊o de Implantes
Na odontologia, nas 繳ltimas d矇cadas tem havido um uso crescente de implantes end籀sseos (in-bone) co
-
Gu矇rison des implants et bio-int矇gration des implants
En dentisterie, au cours des derni癡res d矇cennies, les implants endo-osseux (in-bone) ont 矇t矇 de plu
-
Organic Farming and Bio-Fertilizers
The present book updates the subject content of Organic farming, bio-fertilizers, green chemistry,
-
A Journey Towards Bio-Inspired Techniques in Software Engineering
Springer 出版This book covers a range of basic and advanced topics in software engineering. The field has underg
-
Storage on Bio-Chemical Composition of Bee Bread
Grin Verlag 出版Master's Thesis from the year 2019 in the subject Biology - Zoology, grade: 7.8, course: MSc Zoolog
-
Developpement et Expansion Des Bio-industries
L'objectif de l'ouvrage vise le perfectionnement des proc矇d矇s et des 矇quipements relatifs au d矇velo
-
Bio-Imperialism
Bio-Imperialism focuses on an understudied dimension of the war on terror: the fight against bioter
-
Fungi Bio-Prospects in Sustainable Agriculture, Environment and Nano-Technology
Fungi Bio-prospects in Sustainable Agriculture, Environment and Nanotechnology, Volume Two: Extremo
-
Plant and Animal Bio-Chemistry - Including Information on Amino Acids, Proteins, Pigments and Other Chemical Constituents of Organic Matter
Read Books 出版This antiquarian volume comprises a detailed treatise on the biochemical aspects of plants and anim
-
Transport Across Bio-membrane Using Iontophoresis power supply
Ingram 出版Diffusion is the random motion of the ensemble particles from the higher concentration region to th
-
Bio-ecological studies and management of major insect pests in okra
Ingram 出版Pest complex in okra, sampling techniques, use of botanical and chemical pesticides was evaluated i
-
Fabrication and Analysis of Bio-Inspired Smart Surfaces
This work introduces novel techniques for the fabrication of bio-inspired hierarchical micro- and n
-
Algorithms for Data Mining and Bio-informatics
Ingram 出版Pattern extraction is one of the major topics in the Knowledge Discovery from Data & Background Kno
-
Effect of Bio-Organics and Mineral Nutrients on Sprouting Broccoli
The book "Effect of Bio-Organics and Mineral Nutrients on Sprouting Broccoli" is a useful guide for
-
BIO-MOLECULES -Text Book for B Sc., Biotechnology Students
Ingram 出版About the book - BIO-MOLECULES, The book is an integrated approach to encompass information on the
-
Bio-based Building Skin
Ingram 出版This book provides a compendium of material properties, demonstrates several successful examples of
-
Einstellung und Verhalten beim Konsum von BIO-Lebensmitteln
Inhaltlich unver瓣nderte Neuauflage. Seit im Jahr 2000 der 1. Fall von BSE in Deutschland amtlich be
-
Necesidades de Capacitaci籀n en Bio矇tica
La terapia dial穩tica es uno de los principales m矇todos de tratamiento para los pacientes con enferm
-
Bio-Chemical Analysis of Processed Food Groups and Their Snacks
The chemical and bio-chemical composition of foods is fundamental to the study of their properties
-
Religiosidad m矇dica y bio矇tica
Mucho se conoce sobre la influencia de la devoci籀n religiosa de los pacientes sobre la enfermedad.
-
Concep癟繭es Bio矇ticas
A presente obra aborda os principais aspectos que afectam directamente na sa繳de do homem devido a c
-
Quality of Fish Fillet with Bio-polymer Coating
Reef cod is one of the most highly esteemed table fish of India both from the point of view of cons
-
Marketingstrategien f羹r Bio-Lebensmittel
Inhaltlich unver瓣nderte Neuauflage. Der Markt f羹r Bio-Lebensmittel w瓣chst best瓣ndig. Trotzdem ist d
-
Bio Degradable Polymer Nano Composite
The plastics used by food packing industries are usually fabricated from polyolefins which are comp
-
Molecular studies and bio-applications for Halo tolerant bacteria
Extermophilic microorganisms have a unique ability to live in extreme environments and deliver a va
-
Performance Improvement of Bio-diesel Engine
The rapid depletion of fossil fuel with increased environmental concern has increased efforts to pr
-
Effect on Salinity on Bio-chemical Parameters of Pearl Millet
Extend of saline area in Gujarat is 12,18,255 ha. (CSSRI, Extend and distribution of saline and alk
-
Analysis on Bio-Mathematics
This book is special for the Bio analysis in context of study on blood pressure and helpful in oper
-
Characterization of Bio-physical Parameters in a Micro-watershed
ICRISAT has adopted one of the watershed covering nearly 5000 ha area for developing it as site of
-
Bio-Medical Instrumentation
This book "Bio-Medical Instrumentation" covers the theory and applications of biomedical instrument
-
Segmentation d’images m矇dicales par les algorithmes bio-inspir矇s
Dans le cadre de cette th癡se, nous avons focalis矇 notre 矇tude sur la segmentation automatique des i
-
Pharmacological Study of Bio active Heterocyclic compounds
The book entitled "Pharmacological Study of Bio active Hetero cyclic compounds" has been divided in
-
Feasibility of Treating Brewery Wastewater Using Bio Films
The book explores the use of moving bed bio-film technology to reclaim brewery effluent for plant u
-
Bio-Osseous Bone Grafts
Bone is unique in its inherent capability to completely regenerate without scar tissue formation. T
-
Pollution signatures on Bio-indicators (Foraminifera)
Ingram 出版The Department of Geology at Sri Venkateswara University, Tirupati is one of the pioneering institu
-
Imaging the Bio-Field
This innovative research demonstrates it is possible to image the 'Qi' of the body in a repeatable
-
Optimization and Kinetics of Bio-Diesel Production
Ingram 出版This book covered the general information comprises of work-done in castor oil extraction using sox
-
Use of Bio-catalysts to optimize Biogas systems
Biogas production in developing nations face a lot of challenges including low yields and calorific
-
Bio-Materials Science and Engineering
Biomaterials are being used for the healthcare applications from ancient times. But subsequent evol
-
Improving Android’s Device Security using Behavioral Bio-metrics
Ingram 出版Mobile phone technology dominantly controls our daily life whether for solemn business matter or fo
-
Fast Pyrolysis of an agricultural residue for bio energy products
Ingram 出版Bio-energy products from agricultural biomass residue such as paddy husk is an attractive option du
-
Effect Of Some Bio-chemical
On-farm field experiments were conducted to assess the impacts of some nitrogen (N) and phosphorus
-
Bio矇tica Y Conflictos Por La Hidroelectricidad En Colombia
Al momento de hacer una gesti籀n adecuada alrededor de los recursos naturales es necesario actuar co
-
-
Bio number 3. Grouchy.
Blurb 出版It's a book, like all my books, with musings, illustrations and photographs of me young and now. An